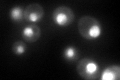
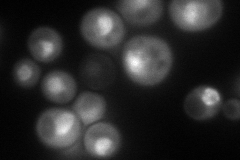
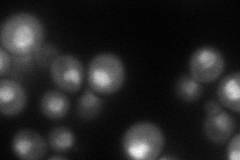
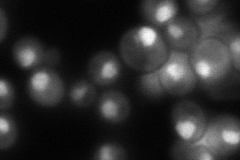
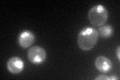

View description
Essential, non-ATPase regulatory subunit of the 26S proteasome lid, similar to mammalian p55 subunit and to another S. cerevisiae regulatory subunit, Rpn7p
Localization:
Intensity:
Fold change:
Significance:
-
C’ GFP library in SD
nucleus146.93 -
N' NOP1pr-GFP in SD
nucleus119.258 -
N' TEF2pr-mCherry in SD
nucleus82.3878 -
N' NATIVEpr-GFP in SD
nucleus141.156 -
N' TEF2pr-VC and Cyto-VN in SD

#N/A0 -
C’ GFP library in SD+DTT

nucleus177.81.21No -
C’ GFP library in SD+H2O2

nucleus186.81.27No -
C’ GFP library in Starvation Media
nucleus136.740.93No -
C’ GFP library on the background of Pup2-DaMP

nucleus -
C’ GFP library on the background of CCT mutant

nucleus171.81.16917No
